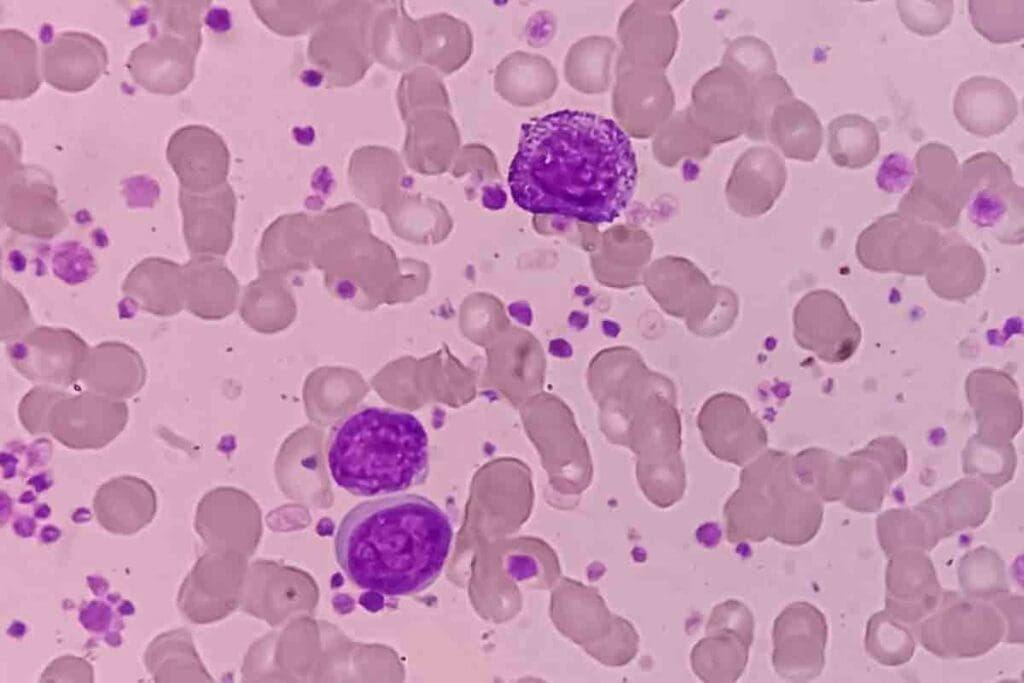
Symptoms of Leukemia Petechiae: 11 Key Signs 1 Symptoms of Leukemia Petechiae: 11 Key Signs

Last Updated on November 20, 2025 by Ugurkan Demir
Leukemia is a cancer that affects the blood and bone marrow. It causes symptoms that can be subtle yet significant. One key sign is petechiae, which are small, painless spots on the skin.Learn symptoms of leukemia petechiae and skin changes to watch for early detection and medical care.
At Liv Hospital, we know how important it is to spot these symptoms early. This helps us diagnose and treat leukemia quickly.
Leukemia can show up differently depending on the type. Common signs include fever, persistent fatigue, and easy bruising. It’s vital for patients to know these symptoms to get medical help fast.
Our trusted protocols at Liv Hospital aim to provide clear and thorough care. We help patients understand blood cancers and their visible signs.
Key Takeaways
- Leukemia can cause a variety of skin changes, including petechiae.
- Early recognition of leukemia symptoms is key for timely treatment.
- Liv Hospital offers complete care for international patients.
- Persistent fatigue and easy bruising are common leukemia signs.
- Knowing leukemia symptoms can lead to quick medical attention.
Understanding Leukemia and Its Effects on the Body

Leukemia is a complex condition that affects the body’s blood-forming tissues. It leads to various health complications. This type of cancer starts in the bone marrow and lymphatic system, impacting blood cell production.
What Is Leukemia?
Leukemia is cancer of the body’s blood-forming tissues. It affects the bone marrow and the lymphatic system. It impacts the production of blood cells, leading to abnormal white blood cells in the bone marrow.
Types of Leukemia:
- Acute Lymphocytic Leukemia (ALL)
- Acute Myeloid Leukemia (AML)
- Chronic Lymphocytic Leukemia (CLL)
- Chronic Myeloid Leukemia (CML)
How Leukemia Affects Blood Cell Production
Leukemia disrupts the production of platelets, red blood cells, and white blood cells. Platelets are key for blood clotting. Red blood cells carry oxygen, and white blood cells fight infections. In leukemia, abnormal white blood cells crowd out normal cells, causing complications.
| Blood Cell Type | Normal Function | Effect of Leukemia |
| Platelets | Blood Clotting | Low Platelet Count (Thrombocytopenia) |
| Red Blood Cells | Oxygen Transport | Anemia |
| White Blood Cells | Fighting Infections | Abnormal Cells, Impaired Immune Function |
The Connection Between Leukemia and Skin Manifestations
Leukemia can show through various skin symptoms. These include petechiae, easy bruising, rash, mouth sores, and frequent skin infections. The disease’s impact on blood cell production, mainly platelets, is the reason for these symptoms.
“The skin manifestations in leukemia are a result of the underlying hematological disorder, which affects the production of blood cells and platelets, leading to bleeding tendencies and immune system dysfunction.”
Understanding the link between leukemia and its skin symptoms is key. These symptoms can be an early warning sign. They prompt individuals to seek medical attention.
Recognizing the Symptoms of Leukemia Petechiae

One of the key symptoms of leukemia is the appearance of petechiae on the skin. These are small, painless spots that show up when tiny blood vessels break under the skin. They can be red, brown, or purple.
What Are Petechiae?
Petechiae are tiny spots that are less than 2 millimeters across. They can appear on various parts of the body, including the legs, feet, stomach, or trunk. They are often an early sign of leukemia, as they can indicate a low platelet count, which is common in leukemia patients.
These spots are not itchy or painful but can be a cause for concern. If you notice petechiae, it’s essential to consult a healthcare provider to determine the underlying cause.
How Low Platelet Counts Lead to Petechiae
Leukemia can affect the bone marrow’s ability to produce platelets, leading to thrombocytopenia or low platelet count. Platelets are vital for blood clotting. When their count is low, even minor injuries can cause bleeding under the skin, resulting in petechiae.
Key factors that contribute to petechiae in leukemia:
- Low platelet count due to bone marrow suppression
- Increased risk of bleeding
- Breakage of small blood vessels
Distinguishing Petechiae from Other Skin Conditions
Petechiae can be confused with other skin conditions such as rashes or bruises. There are distinct characteristics that can help differentiate them:
| Characteristics | Petechiae | Other Skin Conditions |
| Appearance | Small, pinpoint spots | Varying sizes and shapes |
| Color | Red, brown, or purple | Can vary widely |
| Texture | Flat | Can be raised or flat |
“Petechiae are a significant sign that warrants medical evaluation, specially if they appear in conjunction with other symptoms like fatigue or unexplained bruising.”
Understanding the characteristics of petechiae and their connection to leukemia can help in early detection and treatment. If you’re concerned about petechiae or other skin changes, consult a healthcare professional for proper evaluation and care.
Common Locations for Leukemia Petechiae
Knowing where leukemia petechiae show up can help spot them early. These small spots on the skin are from tiny blood vessel bleeding. They can pop up anywhere on the body.
Leukemia Petechiae on Feet
Feet are a common spot for leukemia petechiae. You might see them on the soles or around the ankles. Seeing these spots can mean your platelet count is low, a sign of leukemia.
Leukemia Petechiae on Stomach and Trunk
Petechiae can also show up on the stomach and trunk. These spots are often seen because of skin pressure. In leukemia patients, they signal the disease’s effect on blood cells.
Petechiae on Legs and Thighs
Leukemia petechiae can also appear on the legs and thighs. These spots might come with symptoms like tiredness or pain. These symptoms can change over time.
Dark Spots on Spine and Other Unusual Locations
Sometimes, petechiae show up on the spine or other unusual places. These are less common but very telling of leukemia’s impact. If you notice unusual spots or rashes, see a doctor right away.
Doctors say, “Petechiae are a common sign of bleeding disorders, like leukemia.” Spotting these symptoms early can lead to quick medical help.
| Common Locations | Characteristics |
| Feet | Petechiae on soles or around ankles |
| Stomach and Trunk | Petechiae due to skin pressure |
| Legs and Thighs | Accompanied by fatigue or pain |
| Spine and Other Areas | Less common but significant indicators |
Other Skin Changes Associated with Leukemia
Leukemia can show up in different ways on the skin, which is important for catching it early. These changes happen because leukemia messes with how blood cells are made. This leads to different skin problems.
Easy Bruising and Prolonged Bleeding
Easy bruising is a common sign of leukemia. It happens because leukemia affects platelets, which help blood clot. When there aren’t enough platelets, even small injuries can cause big bruises. Also, bleeding that doesn’t stop right away can be a sign of leukemia.
Leukemia Rash Characteristics
A rash from leukemia, called leukemia cutis, looks like red or purple spots on the skin. It happens when leukemia cells get into the skin. The rash can look different, but it’s often firm, red-brown to purple spots or bumps.
Mouth Sores and Oral Manifestations
Mouth sores are another sign of leukemia. People with leukemia might get ulcers, swollen gums, and bleeding in the mouth. These problems happen because there aren’t enough white blood cells to fight off infections.
Increased Susceptibility to Skin Infections
People with leukemia often get sick easier because their immune system is weak. They can’t fight off infections as well because they don’t have enough healthy white blood cells. This leads to more skin problems.
In short, leukemia can cause many skin changes that are key to spotting. Knowing these signs can help patients get help sooner. This might make their treatment better.
Blood Count Abnormalities in Leukemia
Leukemia often causes abnormal blood counts. This affects white blood cells, red blood cells, and platelets. These changes can lead to serious problems and help doctors diagnose the disease.
High White Blood Cell Count and Its Significance
A high white blood cell count is common in leukemia patients. White blood cells fight infections, but in leukemia, they can be too many or not work right. This can mean leukemia or other issues like infections or inflammation.
The Leukemia & Lymphoma Society says a high white blood cell count is common in leukemia. This is true for chronic myeloid leukemia (CML) and acute myeloid leukemia (AML).
Does Elevated White Blood Cell Count Mean Cancer?
An elevated white blood cell count doesn’t always mean cancer. It can also be due to infections, allergies, or inflammatory diseases. A detailed medical check is needed to find out why the count is high.
Low White Blood Cell Count and Increased Infection Risk
Some leukemia patients have a low white blood cell count, or leukopenia. This makes them more likely to get infections because their body can’t fight off germs well. Leukopenia can be caused by leukemia itself or by treatments like chemotherapy.
Other Blood Cell Abnormalities in Leukemia
Leukemia also affects red blood cells and platelets. Anemia, which is low red blood cell count or hemoglobin, is common. It can cause fatigue, weakness, and shortness of breath. Thrombocytopenia, or low platelet count, can lead to easy bruising and bleeding.
| Blood Cell Type | Abnormality | Potential Complications |
| White Blood Cells | High or Low Count | Increased infection risk, leukemia |
| Red Blood Cells | Anemia (Low Count or Hemoglobin) | Fatigue, weakness, shortness of breath |
| Platelets | Thrombocytopenia (Low Count) | Easy bruising, bleeding |
It’s important to understand these blood count changes to manage leukemia well. Regular blood tests help catch these issues early. This allows for quick action to help the patient.
Pain and Discomfort Symptoms in Leukemia
Leukemia can cause pain and discomfort, affecting a patient’s life quality. Pain is different for everyone with leukemia.
Types of Pain Associated with Leukemia
Leukemia can lead to bone, joint, and abdominal pain. Bone pain happens when leukemia cells fill the bone marrow, causing discomfort. Joint pain comes from leukemia cells in the joints or nearby tissues.
Abdominal pain might be due to enlarged spleen or liver, common in some leukemia types. Knowing these pain types helps in managing them better.
Does Leukemia Pain Come and Go?
Yes, leukemia pain can change, coming and going. This change is tied to the disease’s progress and treatment success. Patients may feel better and then worse again.
Telling doctors about pain levels is key to better treatment plans. Effective pain management greatly improves life quality.
Leg Pain and Leukemia
Leg pain is common in leukemia, often from bone or joint issues. Leukemia cells in leg bones can cause pain, from mild to severe. Sometimes, there’s swelling or redness too.
If leg pain is constant or severe, see a doctor. They can find the cause and start the right treatment.
When to Seek Medical Attention for Pain
Leukemia patients should see a doctor for ongoing, severe, or getting worse pain. Pain that stops you from doing daily things or sleeping should be reported.
Seeing a doctor early can help manage pain better. Don’t be shy about talking about pain with your healthcare team. They can adjust treatments to help a lot.
Fatigue and Other Systemic Symptoms
Fatigue is a big problem for many leukemia patients. It makes their life much harder. This tiredness is not just feeling a bit sleepy. It’s a deep lack of energy that makes everyday tasks hard.
Understanding Leukemia-Related Fatigue
Leukemia-related fatigue comes from many sources. Anemia is a big one, because it means not enough red blood cells. These cells carry oxygen to our bodies.
It’s tough to deal with fatigue, but knowing why it happens helps. Doctors can then find ways to help patients feel more energetic and live better lives.
The Fluctuating Nature of Leukemia Symptoms
Leukemia symptoms, like fatigue, can change a lot. Some days are better, but others are worse. This can happen because of the disease itself, or because of treatments.
It’s important for patients to know that symptoms can come and go. Keeping a journal of symptoms can help track changes. This can be really helpful in managing the disease.
Connection Between Fatigue and Blood Cell Abnormalities
Fatigue is closely linked to blood cell problems in leukemia. Low white blood cell counts make infections more likely, which makes us tired. Anemia, or low red blood cells, also makes us feel very tired because our bodies don’t get enough oxygen.
| Blood Cell Abnormality | Effect on Patient | Potential Intervention |
| Anemia (Low Red Blood Cell Count) | Fatigue, weakness, shortness of breath | Blood transfusions, iron supplements |
| Low White Blood Cell Count | Increased infection risk, fatigue | Growth factors to stimulate white blood cell production |
| Thrombocytopenia (Low Platelet Count) | Bleeding, bruising, petechiae | Platelet transfusions |
Knowing how blood cell problems affect fatigue is key. Doctors can then work to fix these problems. This helps patients feel better and live better lives.
Differentiating Leukemia from Other Conditions
It’s important to tell leukemia apart from other health issues for the right treatment. Leukemia symptoms can look like other problems, making it hard to diagnose without a detailed check-up.
Iron Deficiency vs. Leukemia
Iron deficiency anemia can cause symptoms like fatigue and weakness, just like leukemia. But, iron deficiency is about not having enough iron in the body. It’s different from leukemia, which affects blood cells.
Key differences between iron deficiency and leukemia:
- Iron deficiency is treated with iron supplements, while leukemia needs treatments like chemotherapy.
- Iron deficiency anemia doesn’t usually change blood cell counts much. Leukemia, on the other hand, often does.
Other Cancers That Cause High White Blood Cell Count
High white blood cell counts can also be seen in other cancers. For example, lymphoma and myeloproliferative neoplasms can cause this. Finding out why the count is high is key to the right treatment.
Cancers that can cause high white blood cell count:
- Lymphoma
- Myeloproliferative neoplasms
- Chronic myeloid leukemia (CML)
Non-Cancerous Conditions That Mimic Leukemia Symptoms
Some non-cancerous conditions can also look like leukemia. These include infections, autoimmune disorders, and other blood problems. For instance, infectious mononucleosis can cause symptoms similar to leukemia.
When to Consult a Healthcare Provider
If you have symptoms that might be leukemia, see a doctor. Early treatment is very important for leukemia patients.
Signs that you should seek medical attention:
- Persistent fatigue or weakness
- Unexplained weight loss
- Frequent infections
- Easy bruising or bleeding
We stress the need to see a healthcare provider for a correct diagnosis and treatment. By knowing the difference between leukemia and other conditions, we can give patients the best care.
Conclusion: Recognizing the Warning Signs and Taking Action
It’s key to spot the early signs of leukemia to get treatment fast. We’ve talked about symptoms like petechiae and skin changes that might mean you have this disease. Knowing these signs helps people get medical help early.
Spotting leukemia symptoms early can really help with treatment. It’s important to watch for signs like petechiae, easy bruising, and skin changes. If you notice anything odd or it keeps happening, see a doctor right away.
Being alert to leukemia symptoms lets people take charge of their health. We stress the need to know about petechiae and other skin symptoms. This way, you can get the right care quickly and have a better chance of recovery.
FAQ
What are the common skin symptoms of leukemia?
Leukemia can lead to several skin symptoms. These include petechiae, easy bruising, and a rash. Petechiae are small spots on the skin due to low platelet counts.
What is leukemia petechiae and where does it typically appear?
Leukemia petechiae are small, red or purple spots from bleeding under the skin. They can show up on the feet, stomach, trunk, legs, thighs, and more.
Does leukemia cause pain, and can it come and go?
Yes, leukemia can cause pain. The pain’s intensity and location can change. If you have persistent or severe pain, see a doctor.
Can leukemia symptoms come and go, or are they persistent?
Symptoms of leukemia can vary. Some people have symptoms that change, while others have them all the time. It depends on the disease’s progression.
What is the connection between high white blood cell count and leukemia?
A high white blood cell count might mean leukemia. But, it can also be from infections or inflammation. It’s not always cancer.
Does a high white blood cell count always mean cancer?
No, a high white blood cell count doesn’t always mean cancer. It can be from leukemia, infections, inflammation, or other conditions.
Can iron deficiency cause symptoms similar to leukemia?
Yes, iron deficiency can cause symptoms like fatigue, weakness, and pale skin. But, it’s a different condition that needs its own treatment.
How can I differentiate between leukemia and other conditions with similar symptoms?
You should see a doctor for a proper diagnosis. Leukemia symptoms can be like other conditions. A doctor will do tests to find out what’s causing your symptoms.
What are the causes of fatigue in leukemia patients?
Fatigue in leukemia patients can come from anemia, low red blood cells, or blood cell problems. The disease and its treatment also contribute to fatigue.
Can leukemia cause dark spots on the spine or other unusual locations?
Yes, leukemia can cause spots or skin changes in unusual places, like the spine. But, you should see a doctor to find out why.
Is leukemia painful, and how can pain be managed?
Leukemia can be painful. Pain can be managed with medicines, radiation, or other treatments. Talk to your doctor about managing your pain.
Reference
- PMC. (2023). Leukemia cutis—The current view on pathogenesis, clinical features, and treatment. https://pmc.ncbi.nlm.nih.gov/articles/PMC10670312/